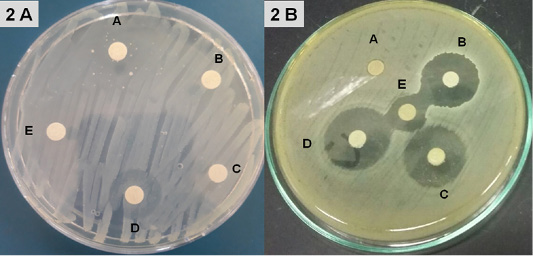

Advances in Animal and Veterinary Sciences
PCR products of amplified of hemolytic non-hemolytic enterotoxin virulent genes identified in B. cereus visualized on agarose gel electrophoresis. The expected molecular size of amplified DNA: 237 bp for hblA gene (A), 386 bp for hblC gene (B), 436 bp for hblD gene (C), 475 bp for nheA gene (D), 328 bp for nheB gene (E) and 557 bp for nheC gene (F). Lane 1-9: samples and Lane (L) DNA ladder 100 bp.
Fig. 2 A from A-E samples of disc diffusion test for Amoxicillin, Ampicillin, Cephalexin, Chloramphenicol, Penicillin; 2 B from A-E samples of disc diffusion test for Tetracycline, Ciprofloxacin, Gentamicin, Streptomycin, Erythromycin.
Log Reduction Values of Disinfectants-Treated B. cereus in suspension at various concentrations and contact times under clean /dirty dairy environment condition.
Antibacterial activity of CCP and CWP and its pepsin hydrolysates against B. cereus at different concentrations. The data is presented as log CFU/ml. (Inset) Killing power of algae extracts (2000, 1000 and 500 µg/ml) against Bacillus cereus. The assays were performed in triplicate.
Antibiogram resistance pattern of B. cereus isolates.